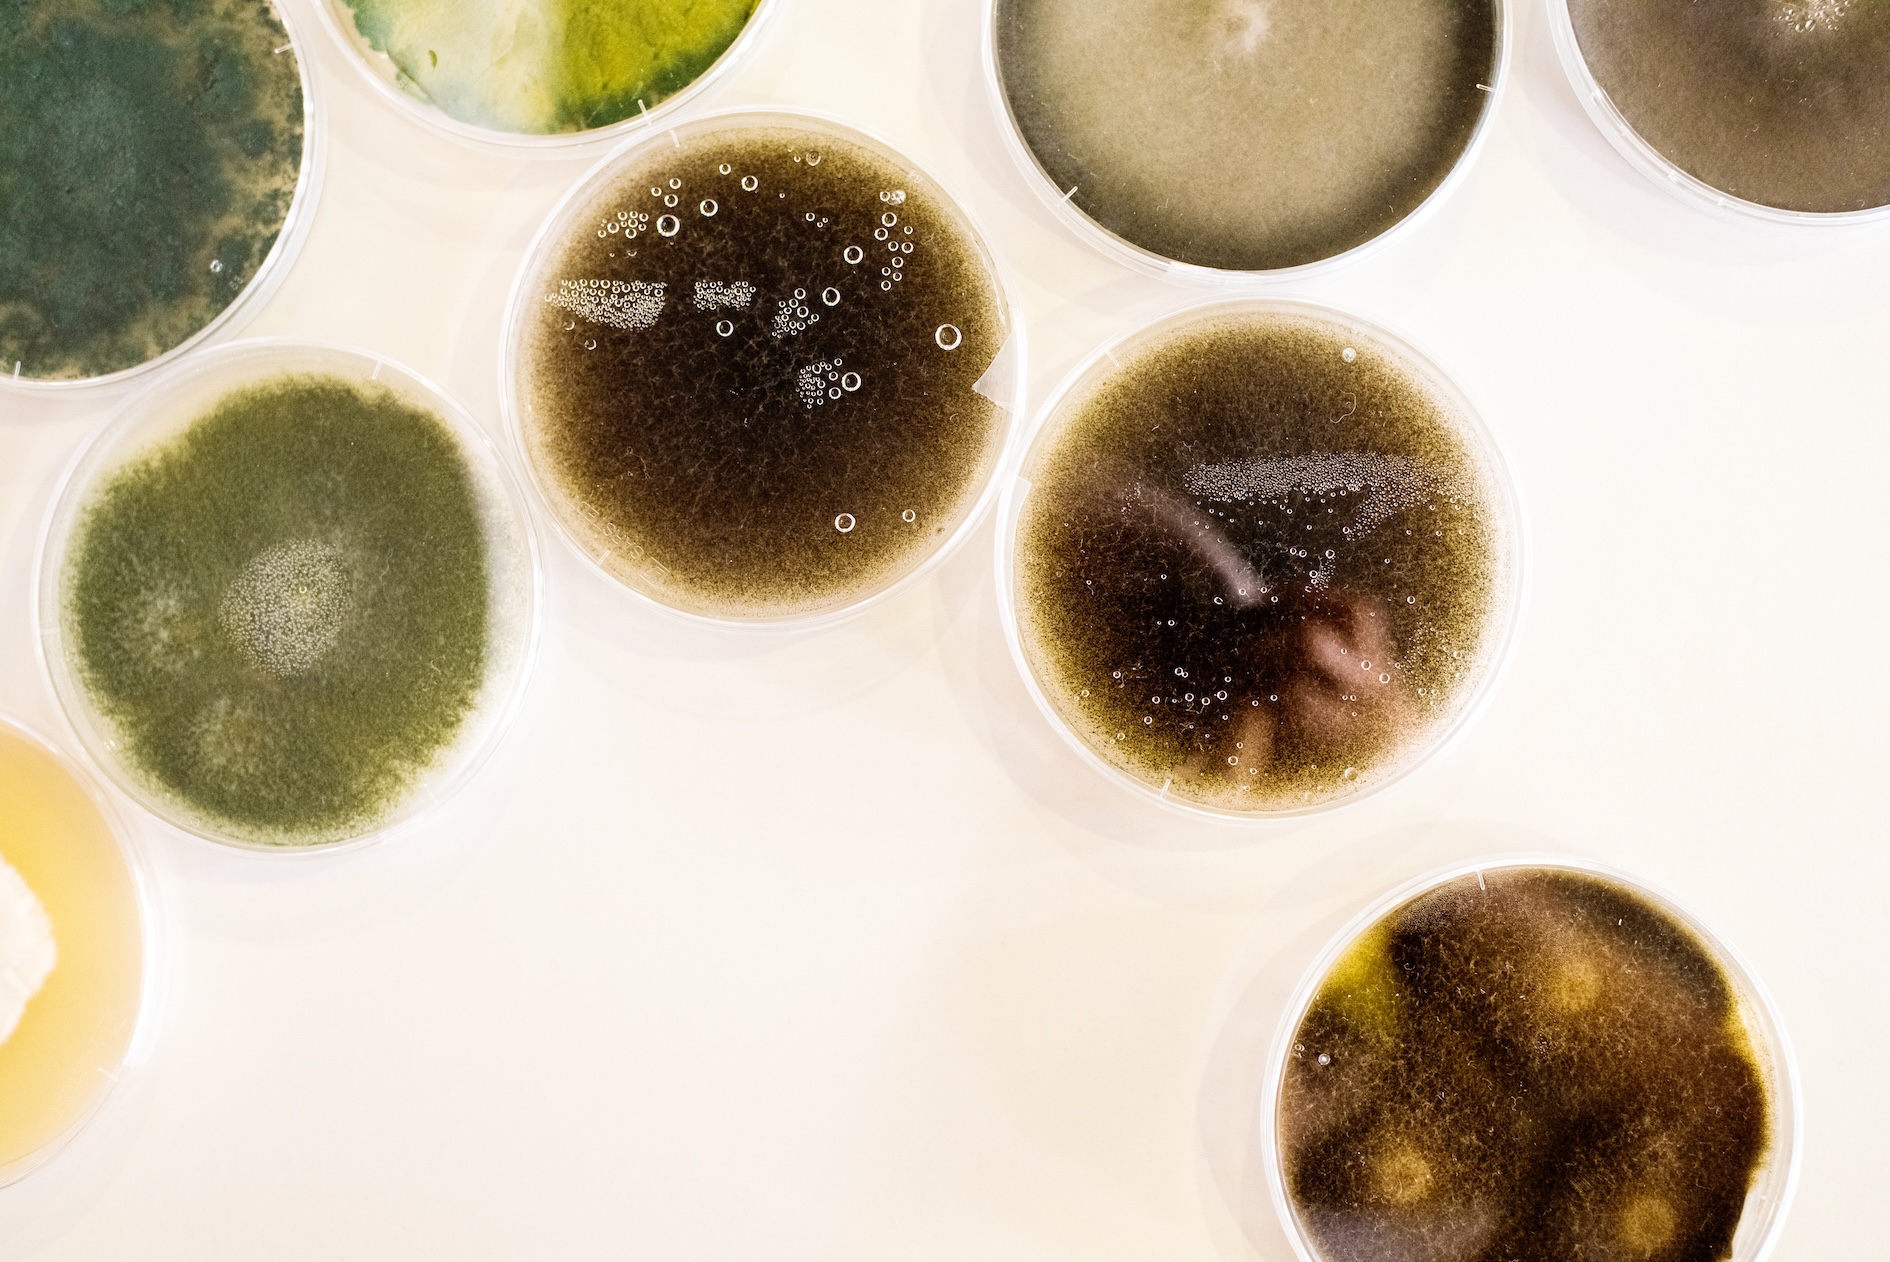

Una nuova relazione congiunta dell’EFSA e del ECDC segnala che la resistenza agli antimicrobici (AMR) nei principali batteri di origine alimentare, in particolare Salmonella e Campylobacter, resta un problema rilevante per la salute pubblica in Europa.
Secondo il rapporto, questi batteri continuano a mostrare livelli significativi di resistenza ai farmaci comunemente utilizzati, pur in un contesto in cui alcuni Paesi hanno registrato miglioramenti misurabili.
Diffusione e impatto sulla salute pubblica
I batteri di origine alimentare possono trasmettersi dagli animali all’uomo attraverso la filiera alimentare e causare infezioni anche gravi. In questi casi può rendersi necessario un trattamento antimicrobico, con efficacia però ridotta quando è presente resistenza ai farmaci.
L’analisi evidenzia quindi la persistenza del problema in un quadro epidemiologico eterogeneo tra Stati membri, specie in relazione alle pratiche di utilizzo degli antimicrobici e alle misure di prevenzione adottate nei diversi sistemi produttivi.
Resistenza ai principali antimicrobici
Una quota elevata di Salmonella e Campylobacter isolati sia nell’uomo sia negli animali da produzione alimentare mostra resistenza alla ciprofloxacina, uno degli antimicrobici utilizzati nei casi di infezione grave.
Per Campylobacter, la diffusione della resistenza è ormai tale che la ciprofloxacina non è più raccomandata come trattamento standard delle infezioni umane in Europa. Di conseguenza, il suo impiego negli allevamenti è stato progressivamente limitato per preservarne l’efficacia in ambito clinico.
Nel caso della Salmonella, la resistenza negli animali da produzione alimentare risulta stabilmente elevata, mentre nelle infezioni umane si registra un aumento negli ultimi anni.
Resistenza diffusa ad altri antimicrobici
Oltre alla ciprofloxacina, il rapporto rileva livelli elevati di resistenza anche verso antimicrobici di uso comune come ampicillina, tetracicline e sulfamidici. Il fenomeno interessa sia i ceppi isolati nell’uomo sia quelli negli animali destinati alla produzione alimentare.
Segnalazioni su E. coli e carbapenemasi
Un ulteriore elemento evidenziato riguarda il rilevamento di Escherichia coli produttori di carbapenemasi in animali da allevamento e nella carne in diversi Paesi europei.
I carbapenemi sono considerati antimicrobici di ultima linea in medicina umana e non risultano autorizzati per l’uso negli animali da produzione alimentare. L’aumento delle segnalazioni e l’incertezza sulle fonti di diffusione richiedono ulteriori approfondimenti.
Tendenze recenti e segnali di miglioramento
Accanto ai livelli ancora elevati di resistenza, il rapporto segnala anche tendenze di miglioramento in diversi contesti nazionali.
Per Salmonella si osserva una riduzione della resistenza all’ampicillina e alle tetracicline in numerosi Paesi europei nel corso dell’ultimo decennio. Anche negli animali da produzione alimentare si registrano diminuzioni della resistenza, in particolare nei polli da carne e nei tacchini.
Per Campylobacter, la resistenza all’eritromicina — utilizzata come trattamento di prima linea nelle infezioni umane — è diminuita in diversi Paesi sia nei casi umani sia in alcuni comparti zootecnici.
Stabilizzazione e rallentamenti in alcune aree
In alcune categorie, come E. coli nel pollame, il rapporto evidenzia una fase di stabilizzazione dei livelli di resistenza dopo precedenti riduzioni.
In generale, la resistenza combinata a più antimicrobici di importanza critica rimane su livelli bassi per Salmonella, Campylobacter ed E. coli, pur con variazioni tra Paesi e comparti produttivi.
Differenze tra Paesi e fattori di influenza
Le differenze nei livelli di resistenza tra Paesi riflettono una pluralità di fattori, tra cui modalità di impiego degli antimicrobici, pratiche di allevamento, misure di biosicurezza e strategie di prevenzione delle infezioni.
Il quadro complessivo evidenzia un andamento non uniforme, con progressi in alcuni contesti e criticità persistenti in altri.
Approccio integrato tra sanità umana e animale
Le evidenze rafforzano la necessità di un approccio integrato che consideri insieme salute umana, salute animale e sicurezza alimentare, secondo il modello One Health.
L’uso responsabile degli antimicrobici, insieme al rafforzamento delle misure di prevenzione delle infezioni e delle pratiche di sanità animale, viene indicato come elemento centrale per contenere la diffusione dei batteri resistenti e limitare l’impatto sulla salute pubblica europea.